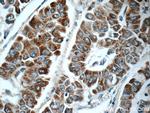
C1orf56 Antibody in Immunohistochemistry (Paraffin) (IHC (P))

Search
Proteintech
C1orf56 Polyclonal Antibody
{{$productOrderCtrl.translations['antibody.pdp.commerceCard.promotion.promotions']}}
{{$productOrderCtrl.translations['antibody.pdp.commerceCard.promotion.viewpromo']}}
{{$productOrderCtrl.translations['antibody.pdp.commerceCard.promotion.promocode']}}: {{promo.promoCode}} {{promo.promoTitle}} {{promo.promoDescription}}. {{$productOrderCtrl.translations['antibody.pdp.commerceCard.promotion.learnmore']}}
产品信息
25433-1-AP
种属反应
宿主/亚型
分类
类型
抗原
偶联物
形式
浓度
规格
纯化类型
保存液
内含物
保存条件
运输条件
产品详细信息
This antibody detects the endogenous protein (35 kDa) in mouse testis. The identity of an additional 65 kDa band is unknown.
Immunogen sequence: MVPAAGALL WVLLLNLGPR AAGAQGLTQT PTEMQRVSLR FGGPMTRSYR STARTGLPRK TRIILEDEND AMADADRLAG PAAAELLAAT VSTGFSRSSA INEEDGSSEE GVVINAGKDS TSRELPSATP NTAGSSSTRF IANSQEPEIR LTSSLPRSPG RSTEDLPGSQ ATLSQWSTPG STPSRWPSPS PTAMPSPEDL RLVLMPWGPW HCHCKSGTMS RSRSGKLHGL SGRLRVGALS QLRTEHKPCT YQQCPCNRLR EECPLDTSLC TDTNCASQST TSTRTTTTPF PTIHLRSSPS LPPASPCPAL AFWKRVRIGL EDIWNSLSSV FTEMQPIDRN QR (1-341 aa encoded by BC002469)
靶标信息
C1orf56, also named as MENT, AF1Q and MLLT11, is involved in control of cellular proliferation. It is highly expressed in several cancers especially in neuroblastoma.
仅用于科研。不用于诊断过程。未经明确授权不得转售。
生物信息学
蛋白别名: Methylated in normal thymocytes protein; Protein MENT; protein missing in infertile spermatozoa 1; unnamed protein product
基因别名: C1orf56; Gm128; MENT; pmis1; UNQ547/PRO1104
UniProt ID: (Human) Q9BUN1, (Mouse) Q569E4
Entrez Gene ID: (Human) 54964, (Mouse) 229588